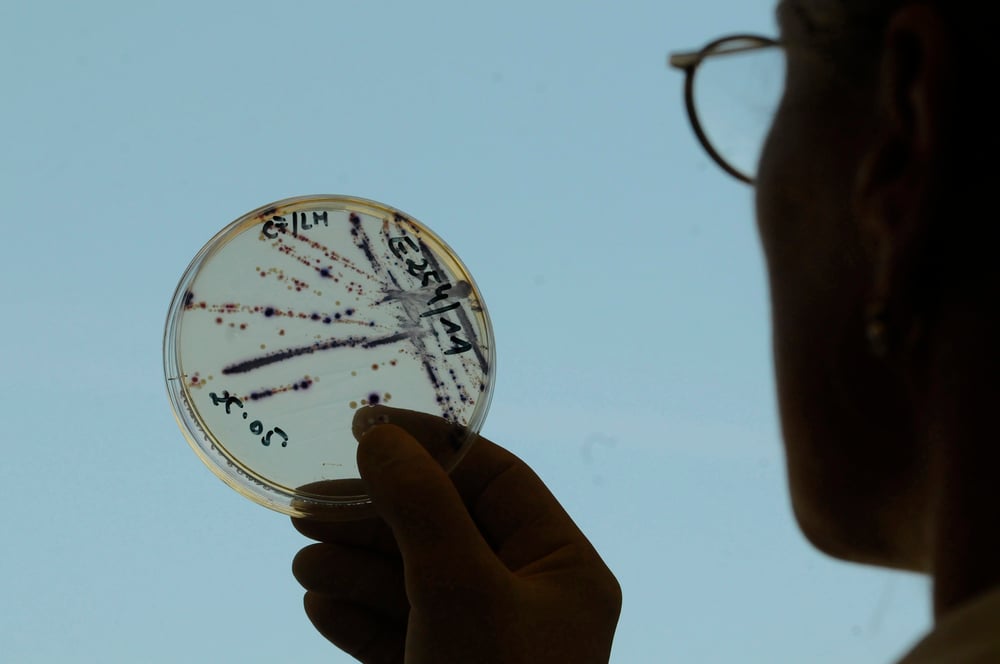

15 Historical Events That Changed Medicine Forever
Medicine has come a long way from the days when doctors believed that illnesses were caused by ‘bad air’ or imbalanced humors. Throughout history, certain pivotal moments have completely transformed how we understand, diagnose, and treat disease — turning what was once considered impossible into everyday medical practice.
These breakthrough moments didn’t just improve healthcare; they revolutionized entire civilizations and saved countless lives. Here is a list of 15 historical events that changed medicine forever.
Discovery of Penicillin (1928)

Alexander Fleming’s accidental discovery of penicillin completely changed the process of drug discovery and extended the average human lifespan by 23 years. When Fleming returned from vacation to find mold growing in his lab dishes, he noticed that bacteria around the mold had died.
This simple observation launched the antibiotic era and transformed how we treat infections. Before penicillin, a simple cut could turn deadly, but this wonder drug made previously fatal infections treatable.
Edward Jenner’s Smallpox Vaccine (1796)

In 1796, British physician Edward Jenner demonstrated that an infection with the relatively mild cowpox virus conferred immunity against the deadly smallpox virus. Jenner’s bold experiment on an eight-year-old boy proved that controlled exposure to a milder disease could prevent a deadlier one.
This concept became the foundation for all modern vaccines. Smallpox remains the only human disease to have been eradicated, and many believe this achievement to be the most significant milestone in global public health.
Like Go2Tutors’s content? Follow us on MSN.
Louis Pasteur’s Germ Theory (1860s)
Before Pasteur, people thought diseases were caused by spontaneous generation or miasma (bad air). His experiments proved that microorganisms cause disease, completely changing medical thinking.
This wasn’t just an academic breakthrough — it revolutionized surgery, food safety, and public health. Suddenly, the invisible world of bacteria and viruses became the enemy we could fight.
Wilhelm Röntgen’s X-Ray Discovery (1895)

The accidental discovery of X-rays by Wilhelm Conrad Roentgen in 1895 enabled physicians to look inside the human body without surgery. Röntgen was experimenting with cathode rays when he noticed a fluorescent screen glowing across the room.
Within weeks, doctors worldwide were using X-rays to see broken bones and locate bullets. This breakthrough opened the door to all modern medical imaging, from CT scans to MRIs.
Introduction of Anesthesia (1846)

Before anesthesia, surgery was a brutal affair that patients often didn’t survive due to shock and pain. William Morton’s public demonstration of ether anesthesia at Massachusetts General Hospital changed everything.
Suddenly, complex surgeries became possible, and patients could undergo procedures without excruciating pain. This single advancement transformed surgery from a last resort to a viable treatment option.
Like Go2Tutors’s content? Follow us on MSN.
Development of the Stethoscope (1816)

René Laennec invented the stethoscope because he felt uncomfortable placing his ear directly on patients’ chests. His wooden tube became the first tool that allowed doctors to hear inside the body.
This simple device revolutionized diagnosis and became the universal symbol of medicine. Before the stethoscope, doctors relied mostly on external symptoms and guesswork.
Discovery of Blood Circulation (1628)

William Harvey’s description of blood circulation overturned centuries of medical beliefs. Ancient physicians thought blood was consumed by organs and constantly regenerated.
Harvey proved that blood circulates through the body in a closed system pumped by the heart. This discovery laid the foundation for modern cardiology and vascular surgery.
Joseph Lister’s Antiseptic Surgery (1867)

Lister applied Pasteur’s germ theory to surgery, introducing carbolic acid as an antiseptic. Before this, surgical infections killed more patients than the original ailments.
His methods dramatically reduced post-operative infections and deaths. Though initially ridiculed by colleagues, Lister’s antiseptic principles became the standard for all medical procedures.
Like Go2Tutors’s content? Follow us on MSN.
Discovery of Insulin (1922)

Frederick Banting and Charles Best’s extraction of insulin from dog pancreases transformed diabetes from a death sentence to a manageable condition. Before insulin, diabetic children wasted away and died within months of diagnosis.
The first successful treatment of a diabetic patient in 1922 marked the beginning of modern endocrinology and saved millions of lives.
Marie and Pierre Curie’s Radioactivity Research (1898)

The Curies’ discovery of radioactivity opened entirely new fields in medicine. Their work led to radiation therapy for cancer and nuclear medicine for diagnosis.
Though they couldn’t have known it, their research would eventually enable PET scans, radioactive tracers, and targeted cancer treatments. Marie Curie’s dedication to science, even at the cost of her health, pushed medicine into the atomic age.
Alexander Fleming’s Discovery of Lysozyme (1922)

Six years before penicillin, Fleming discovered lysozyme, an enzyme that kills bacteria. This earlier discovery came when Fleming’s own mucus (from a cold) accidentally contaminated a bacterial culture.
Though less famous than penicillin, lysozyme research contributed to our understanding of the body’s natural defenses and laid groundwork for antibiotic development.
Like Go2Tutors’s content? Follow us on MSN.
First Successful Heart Transplant (1967)

Christiaan Barnard’s successful heart transplant in South Africa proved that organs could be replaced like mechanical parts. Though the patient survived only 18 days, the surgery demonstrated that the heart wasn’t mystical but functional.
This breakthrough launched the era of organ transplantation and gave hope to patients with end-stage organ failure.
Discovery of DNA Structure (1953)

Watson, Crick, Franklin, and Wilkins’ identification of DNA’s double helix structure revolutionized medicine’s understanding of heredity and disease. This discovery didn’t immediately change treatment but laid the foundation for genetic medicine, gene therapy, and personalized treatments.
Today’s targeted cancer therapies and genetic testing all trace back to this fundamental breakthrough.
Development of the Polio Vaccine (1955)

Jonas Salk’s polio vaccine eliminated a disease that paralyzed thousands of children annually. Unlike previous vaccines that used live viruses, Salk’s used to kill viruses, making it safer.
The successful field trials involved 1.8 million children and proved that careful scientific testing could defeat devastating diseases. This achievement restored public faith in vaccines and medical research.
Like Go2Tutors’s content? Follow us on MSN.
Introduction of Antibiotics in Surgery (1940s)

The widespread use of antibiotics during World War II transformed surgery from a risky procedure to a routine intervention. Surgeons could now operate with confidence, knowing that post-operative infections could be controlled.
This advancement enabled complex procedures like organ transplants and joint replacements. The combination of anesthesia, antiseptics, and antibiotics made modern surgery possible.
How Yesterday’s Breakthroughs Shape Today’s Medicine

These historical moments didn’t just change medicine — they created the foundation for every medical advancement we see today. From Fleming’s moldy petri dish to Jenner’s cowpox experiment, these discoveries remind us that breakthrough moments often come from curiosity, careful observation, and willingness to challenge established beliefs.
The next time you visit a doctor’s office or hospital, remember that you’re benefiting from centuries of medical pioneers who refused to accept that suffering was inevitable.
More from Go2Tutors!

- 16 Historical Figures Who Were Nothing Like You Think
- 12 Things Sold in the 80s That Are Now Illegal
- 15 VHS Tapes That Could Be Worth Thousands
- 17 Historical “What Ifs” That Would Have Changed Everything
- 18 TV Shows That Vanished Without a Finale
Like Go2Tutors’s content? Follow us on MSN.